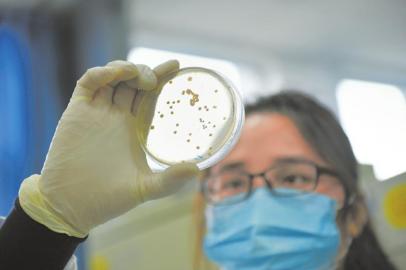

Various bacteria colonies found in the samples. (Photo/www.wccdaily.com.cn)
Ms. Hou, a resident of Xiamen city in east China's Fujian province, noticed red sores festering in her mouth one day after she unwrapped an express parcel with her teeth. Doctors diagnosed it as an allergic reaction, most likely caused by bacteria on the package. Due to instances like this one, some people now believe that there is more bacteria on packages even than on toilet lids and garbage cans.
In order to analyze the bacteria on items in our daily life, reporters from Western China Metropolis Daily connected with two experimental institutions and undertook bacteria testing of express parcels, mobile phones, ATM buttons, elevator buttons and more.
The Chengdu Experimental Center of Medical Research looked at previous data and made a comparison. According to the reports, elevator buttons, ATM buttons and mobile phones had respective bacterial colonies of 2.42, 10.35 and 4.97 per square centimeter.
"In the experiment, we found that the bacteria population on ATM buttons is rather high, and the bacteria colonies on mobile phones are almost ten times that of courier packages. But the superficial areas of express parcels are usually large, so the bacteria population is still not small," said one worker in the research center.
"The more commonly used the items are, the more bacteria they have on their surface, assuming they haven't undergone disinfection. Do not use your mouth to unwrap express parcels. People should wash hands after unpacking parcels and use sterilizing wet tissues to do periodic cleaning of common items," said Peng Shiguo, deputy director of the Fourth People's Hospital of Sichuan Province.
 PLA holds joint air-ground military drill
PLA holds joint air-ground military drill Charming female soldiers on Xisha Islands
Charming female soldiers on Xisha Islands Beautiful skiers wear shorts in snow
Beautiful skiers wear shorts in snow Getting close to the crew on China's aircraft carrier
Getting close to the crew on China's aircraft carrier Chinese stewardess celebrate test flight at Nansha Islands
Chinese stewardess celebrate test flight at Nansha Islands World's first 'underwater skyscraper'
World's first 'underwater skyscraper'  Pentagonal Mart becomes the largest vacant building in Shanghai
Pentagonal Mart becomes the largest vacant building in Shanghai "Rent me as your girlfriend!"
"Rent me as your girlfriend!" A beauty's dancing youth
A beauty's dancing youth Top 20 hottest women in the world in 2014
Top 20 hottest women in the world in 2014 Top 10 hardest languages to learn
Top 10 hardest languages to learn 10 Chinese female stars with most beautiful faces
10 Chinese female stars with most beautiful faces China’s Top 10 Unique Bridges, Highways and Roads
China’s Top 10 Unique Bridges, Highways and Roads Xi arrival shows commitment to Mideast
Xi arrival shows commitment to Mideast Chinese firm aims to build ‘world’s largest cloning factory’
Chinese firm aims to build ‘world’s largest cloning factory’ Qinghai Lake aircraft ban reveals risky trend in wildlife photography
Qinghai Lake aircraft ban reveals risky trend in wildlife photography Foreigners flock to China for cancer, chronic disease treatments
Foreigners flock to China for cancer, chronic disease treatmentsDay|Week